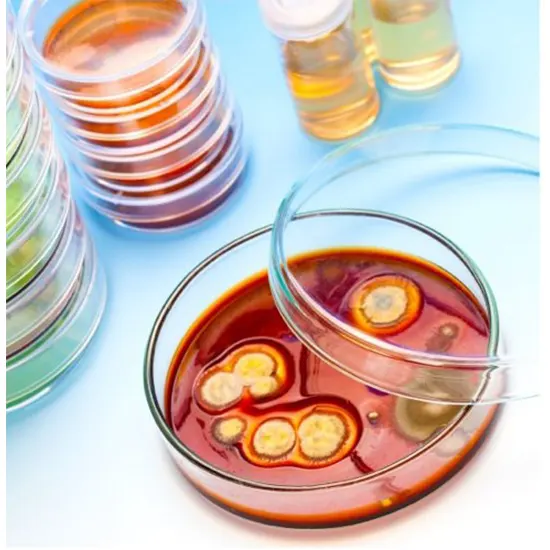

Book Culture Genital Appointment Online Near me at the best price in Delhi/NCR from Ganesh Diagnostic. NABL & NABH Accredited Diagnostic centre and Pathology lab in Delhi offering a wide range of Radiology & Pathology tests. Get Free Ambulance & Free Home Sample collection. 24X7 Hour Open. Call Now at 011-47-444-444 to Book your Culture Genital at 50% Discount.
Sensitivity to culture The pathogen that is now causing vaginal discomfort and discharge is frequently found utilising a vaginal swab. Vaginal discharge is a painful disorder that can result in various symptoms, such asHing as painful urination, discomfort in urethral blood, and Inflammation of the vagina. Virulent discharge Vaginal ring is flaming, burning in and around your genital area. If any of these apply to you, you should seek medical attention away because they may be signs of a more serious health problem.
You must have yourself checked as soon as you start exhibiting some of the symptoms indicated above because this test is primarily used to diagnose and treat vaginal infections.
| Test Type | Culture Genital |
| Includes | Culture Genital (Pathology Test) |
| Preparation | |
| Reporting | Within 24 hours* |
| Test Price |
₹ 1000
|

Early check ups are always better than delayed ones. Safety, precaution & care is depicted from the several health checkups. Here, we present simple & comprehensive health packages for any kind of testing to ensure the early prescribed treatment to safeguard your health.